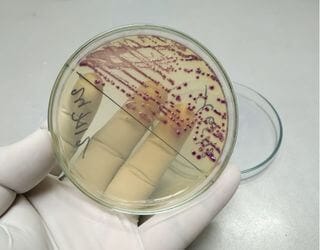
Culture Urine and Sensitivity
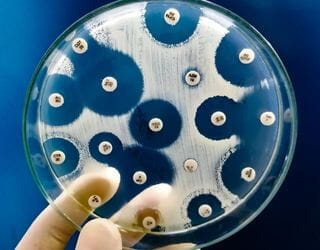
Culture Pus and Sensitivity

Animal Diagnostic Lab You Can Trust
Dog diagnostic centre near Hyderabad
PetYaari Pet Clinic strives to offer the most sophisticated pet diagnostics and veterinary laboratory, which includes animal blood work, serology, hormonal assay, PCR and pet pathology. Routine diagnostic tests are available in-house, enabling us to provide optimal veterinary care for your pet in a timely manner.
Book your pet’s lab test today and give them the care they deserve.
Pet Lab Tests
Our veterinary laboratory is equipped with the latest technology to provide accurate and timely results for all your pet’s diagnostic needs. From blood testing to cytology, we offer a full range of laboratory services to help diagnose and treat your pet’s health issues.
Trusted Labs
Pet diagnostics are done in partnership with Trusted Labs. With this collaboration, pet owners can easily access a range of diagnostic services for their pets at our clinics.
Verified By Doctors
To ensure accuracy, veterinary doctors verify reports before issuing them. This step ensures the proper reliability and interpretation of results, giving pet owners important information about their pets. With this professional verification, pet owners can now trust the diagnostic results and make sound decisions regarding their pets.
Hygiene and Security
We maintain high-level hygiene and sanitation practices for the health and security of the pets. pets’ safety and medical welfare are of utmost priority.

Leading Veterinary Diagnostic Lab in Hyderabad
As one of the most prominent diagnostic labs for veterinary medicine, we offer unmatched quality services for your pets.

Complete Blood Count (CBC)
It includes measurement of some important constituents of blood like the red blood cells, white blood cells and platelets which helps to identify various infections, anaemia and other disease conditions.

Kidney Function Test (KFT)
A kidney function test (KFT) is a set of tests that assesses the functionality of the kidneys. Such tests may include assessing the creatinine, blood urea nitrogen, and electrolyte levels.

Liver Function Test (LFT)
Liver function tests are blood tests that assess the liver’s health, measuring the functionality of specific processes of the liver. Such tests may include the measurement of the enzymatic activities of ALT, AST, ALP, and GGT as well as the levels of bilirubin and albumin.

Thyroid Profile, Total (TSH, fT4, Canine Specific T4)
This test assesses the anatomy and physiology of the thyroid gland by measuring TSH, fT4, and total T4 (Canine Specific T4). The test is indicative of the presence of thyroid disorders and evaluates its function, specifically in canines.

Canine Parvovirus
Canine parvovirus (CPV) is a viral infection with a worldwide distribution that affects dogs and dog-like mammals, particularly their offspring. CPV testing is done by finding viral antigens in a stool sample. Managing the disease focuses on preventing it, alongside timely diagnosis and treatment.

Canine Distemper Virus
Canine distemper is a disease caused by a virus which affects dogs and other animals. To test for distemper, the virus’s RNA must be found in a blood or tissue sample. Preventive vaccination is available.

Canine Ehrlichia Test
Canine erhlichiosis is a disease that is caused by the erlichia species of bacteria through a bite of a tick. The diagnosis of this disease is determined through the detection of antibodies to the bacteria in a sample of blood. The most important things to alleviate this disease is early treatment and tick prevention.

SNAP 4Dx Test
SNAP 4Dx works by carrying out an inquiry to, find out the presence of heartworm, Lyme, ehrlichiosis, and anaplasmosis in dogs’ blood. A very small quantity is used and the examination done within a very short period of time.

Canine Pancreatic Lipase (cPL)
cPL test has been developed to carry out diagnosis of inflammation of the pancreas (pancreatitis). For dogs with pancreatitis, the amount of pancreatic lipase (one of the enzymes secreted by the pancreas) in blood increases. Early detection and treatment is important for this condition.

Feline Pancreatic Lipase (fPL)
The fPL test is performed to rule out the possibility of pancreatitis in cats. It determines the concentration of pancreatic lipase in a blood sample and helps manage care for the patient.

Canine Distemper Detection, PCR
The Polymerase Chain Reaction (PCR) method is employed for the identification of the canine distemper virus (CDV) in blood, tissue, or bodily fluids. Due to its high sensitivity and specificity, PCR serves as an invaluable asset in the diagnosis of this viral infection.

Leptospira, PCR
Leptospira is a bacteria used in diagnosing leptospirosis which affects dogs and various other animals. It can be confirmed through the use of urine or blood samples.

Canine Babesia Detection, PCR
PCR methods are used to identify organisms like Babesia in blood or tissues. This is an important test for the diagnosis of babesiosis in dogs.

Canine Ehrlichia Detection, PCR
Ehrlichia bacteria found in blood or tissue samples can be identified using PCR. This method helps in diagnosing ehrlichiosis in dogs.

Canine Anaplasma Detection, PCR
Anaplasma bacteria are identified by PCR in blood or tissue samples from patients. This test is meant for diagnosing anaplasmosis, a disease that occurs in dogs and is caused by a tick.

Herpes Virus, PCR
PCR identifies herpes virusin blood and other body parts of infected individuals. This test is meant for diagnosing herpes virus infections which affect both dogs and cats.

Feline Disease Panel, PCR (Feline Coronavirus, Feline Infectious Peritonitis)
PCR tests aim to identify feline coronavirus (FCoV) and the feline infectious peritonitis (FIP) from blood and other parts of the body. This panel is used for diagnosing FIP in cats.

Canine Tick-Borne Disease Panel, PCR (Babesia, Ehrlichia, Hepatozoon)
PCR tests check for Babesia, Ehrlichia, and Hepatozoon species in blood or tissue samples. This panel is used for diagnosing tick-borne diseases in dogs.

Canine Tick-Borne Disease Advanced Panel, PCR (Babesia, Ehrlichia, Hepatozoon, Anaplasma)
In blood and other tissues, PCR detects Babesia, Ehrlichia, Hepatozoon, and Anaplasma species. This panel is used to assess several thorn borne diseases in dogs.

FAVN TEST(RABIES ANTIBODY TITER) FOR OVERSEAS TRAVEL
The Fluorescent Antibody Virus Neutralisation test (FAVN) is a blood exam that checks the rabies antibody levels in an animal’s blood. This sort of test is a common requirement when travelling internationally with pets, especially when going to rabies-free or rabies-controlled countries. The FAVN test is critical in assessing whether the pet has enough rabies antibodies to satisfy the entry criteria of the destination country. The specific country’s requirements vary, but typically, a titer of no less than 0.5 IU/ml is expected.

Haemoglobin (Hb)
Haemoglobin (Hb) is a blood component in red blood cells which is responsible for transporting oxygen to all cells within the body. The haemoglobin test determines the concentration of haemoglobin in the blood and can assess the potential of the blood to carry oxygen, alongside identifying the presence of anaemia or other blood disorders.

Hemogram (CBC + ESR)
A hemogram constituent is a blend of the CBC (complete blood count) test and an ESR (Erythrocyte Sedimentation Rate) test. The CBC contains the most important components of blood, and the ESR detects inflammation as well as infection by measuring the rate of red blood cells settling down in a tube of blood.

Albumin, Serum
These proteins are produced by the liver with the primary purpose of ensuring that the blood volume and blood pressure is well controlled. The serum albumin test is performed in a bid to evaluate how much albumin is present in blood because in most cases, it indicates one of the three conditions which include: Liver / Kidney failure, Malnutrition, and other conditions.

Alkaline Phosphatase (ALP)
Alkaline phosphatase is an enzyme also found in the liver and bones including other tissues. ALP test is useful in the diagnosis of both liver and bone disorders since it determines the quantities of this enzyme present in blood and helps find out whether they have higher or lower jaw disorders.

Creatinine, Serum
Creatinine refers to waste generated in metabolism by muscle tissue. During the creatinine serum test, the focus is on checking the blood plasma levels of creatinine, indicating kidney function.

Creatine Kinase (CPK)
Muscle and some other tissues have an enzyme called creatine kinase. A CPK test helps measure the blood level of this enzyme and also indicates muscle damage and certain diseases.

Electrolytes, Serum (Sodium, Potassium, Chloride)
They (electrolytes) are the body’s minerals that help balance fluids, nerves, and muscle function. A serum electrolyte test determines the amount of sodium, potassium and chloride in the blood, which may suggest dehydration and kidney-related disorders among other problems.

Fructosamine
Fructosamine is an adduct of glucose and proteins in serum. A fructosamine test quantifies this compound and assists in estimating blood glucose concentration for the past two to three weeks.

Gamma Glutamyl Transpeptidase (GGT)
Some of the tissues that contain GGT include the liver and bile ducts. A GGT test determines the concentration of this enzyme in the blood, where it may suggest liver or bile duct disorders.

Globulin, Serum
Globulins play an essential role in fighting infections within our body due to their protein composition. A serum globulin test is done to determine the globulin level in blood of the patient. This helps find out if there are any disorders related to the immune system.

Glucose, Fasting
Fasting glucose test is performed to find out glucose level in blood after fasting overnight. It is diagnosed mainly for diabetes in patients, as well as for watching over sugar levels during a certain period of time.

Glucose, Random
A random glucose test measures the blood glucose level at any given time. Like the fasting glucose test, it is also applied for diabetes diagnosis, along with blood sugar regulation.

Iron, Serum
Iron is essential for the creation of haemoglobin, which facilitates carrying oxygen to various cells in the body. Serum iron test is useful when determining the iron content in the blood. Iron deficiency and overload can be easily diagnosed this way.

Lipase, Serum
Lipase is known as one of the enzymes secreted by the pancreas, it is chiefly responsible for fat breakdown. Measuring the concentration of this enzyme in the blood helps understand his/her condition. If this level is high, it means there are chances of pancreatitis or other pancreatic disorders.

Lipid Profile
Lipid profile is a set of tests that checks the concentration of cholesterol and triglycerides within a patient’s blood. It includes evaluations of total cholesterol, HDL cholesterol, LDL cholesterol as well as triglycerides, and is used to estimate the risk of heart disease.

Magnesium, Serum
Magnesium is a bone health associated mineral, it also plays other roles such as muscle and nerve function as well as blood sugar regulation. A magnesium level test measures how much magnesium can be found in the blood, this level can tell if a person has too little or too much magnesium.

Phosphorus, Serum
Phosphorus is known to play a big role in the maintaining healthy bones, generating energy and enhancing the function of cells. A phosphorus blood test evaluates how much phosphorus is in the blood and may help diagnose bone diseases, kidney disorders, and some other illnesses.

Potassium, Serum
Electrolytes are vital in helping with various bodily functions, Potassium stands out as being particularly useful in nerve and muscle activities, and even the heart. A sodium level test indicates how much sodium one has in the body and can reveal kidney issues, dehydration, and other conditions.

Ammonia, Blood
Ammonia is one of the metabolic wastes within the body. Measuring the amount of ammonia found within the blood may assist in identifying liver diseases or other illnesses.

Amylase, Serum
Amylase is one of the pancreatic enzymes responsible for the digestion of carbohydrates. A serum amylase test is performed to measure the amount of serum amylase in the blood which indicates conditions such as pancreatitis or other pancreatic diseases.

Bicarbonate
Bicarbonate is one of the byproducts of respiration whose level reflects the amount of carbon dioxide present in a given blood sample. Furthermore, it is also useful for determining the presence of kidney and respiratory disorders.

Total Protein, Serum
Total protein is a composite of different proteins in the blood; albumin, globulins and others. A total protein serum test assesses the amount of protein found in the blood and is important for evaluating nutrition as well as for liver or kidney diseases and other conditions.

Total Protein, Serum (Albumin, Globulin, A:G Ratio)
This test assesses the concentration of albumin and globulin proteins in blood, measuring the Albumin to Globulin (A:G) ratio as well. Albumin, which serves to maintain blood volume and pressure, is produced by the liver, while globulins, a class of blood proteins, protect the body against infection and perform transport functions. The A:G ratio has potential usefulness in evaluating liver or kidney function, nutritional state, or some other condition.

Phenobarbitone
Phenobarbital is one of the medications used for the treatment of seizures. A phenobarbitone test checks the quantity of phenobarbital in a patient’s blood to ensure it is within the therapeutic range and to monitor for possible adverse effects.

SGOT/AST
Serum glutamic-oxaloacetic transaminase (SGOT), aspartate aminotransferase (AST), is an enzyme associated with the liver as well as several other tissues, including the heart and muscles. An SGOT/AST test determines the amount of this enzyme present in blood, which may reflect liver damage among other things.

SGPT/ALT
Serum glutamic-pyruvic transaminase (SGPT) is also known as alanine aminotransferase (ALT), and it is an enzyme mainly located in the liver. An SGPT/ALT test quantifies the amount of this enzyme and thus helps in the diagnosis of liver diseases.

Sodium, Serum
Sodium is a chemical element that helps to maintain the proper fluid levels within the body, assists in nerve communication, and helps with muscle function. A serum sodium test checks the sodium level in the blood and may show signs of dehydration or problems with the kidneys, among other things.

Triglycerides, Serum
The serum glutamic-oxaloacetic transaminase is an enzyme also referred to as aspartate aminotransferase (AST) and is present in the liver, heart, muscles, and several other parts of the body. An SGOT/AST test has been developed to assess the amount of this enzyme in the blood, which may indicate some sort of damage to the liver or other problems.

Urea, Serum
Urea is a wastage generated from the metabolism of proteins and is eliminated from the blood by the kidneys. Through a serum urea test, the quantity of urea in the blood is assessed as well as the functioning ability of the kidneys.

Uric Acid, Serum
Uric acid is a substance generated from the degradation of purines, which are compounds that can be obtained from some foods and even made by the body itself. Through a serum uric acid test, the volume of uric acid present in the blood is determined along with diagnosing gout and kidney stones among other illnesses.

Vitamin B12 (Cyanocobalamin)
‘Cyanocobalamin test’ and ‘Vitamin B12 test’ refer to the same process: a blood test that assesses vitamin B12 concentration in the blood. Supplementation of B12 is important in a lot of cases as it is one of the necessary nutrients for human beings. B12 sustains blood cell production, contributes to bodily neurological functions, and assists in DNA formulation.

Vitamin D, 25 Hydroxy
Vitamin D is a fat-soluble substance needed for strong bones and circulatory immune system and other activities of the body. A 25-hydroxy vitamin D test determines the amount of this vitamin available and serves as a pointer of its insufficiency or deficiency and other health anomalies.

Culture Blood and Sensitivity (Aerobic)
With this test a blood sample is collected and put into a culture medium to see if any bacteria would grow. The Culture is later analyzed to know the type of bacteria and what antibiotics would kill them (sensitivity testing). This test is useful in observing infections in the blood stream and helps prescribe the right antibiotics.
Culture Urine and Sensitivity
Urine culture consists of obtaining a urine specimen and inoculating it into a suitable medium for the cultivation of any bacteria which may be present. The culture is further identified and the tests done determine which antibiotics are useful to the bacteria identified. This test is usually done to confirm a urinary tract infection (UTI) and for urinary tract infection treatment.

Culture Stool and Sensitivity
The collection of stool specimens and culturing them involves placing the specimen in a medium that encourages the growth of bacteria or other pathogens. The culture is then used to determine the pathogens and establish their sensitivity to antibiotics. This test assists with the diagnosis of gastrointestinal infections, especially those that are not straightforward and managing treatment.
Culture Pus and Sensitivity
Pus culture is the collection of pus matter from an infected wound or abscess and the inoculation of this material into an appropriate culture medium with the aim of finding out what bacteria is present. Culture is done in order to determine which of the bacteria are present and what level of sensitivity they have to antibiotics. This helps in diagnosis and treatment of infections on the skin and soft tissues.

Culture Vaginal Swab and Sensitivity
Vaginal culture involves collecting a sample from the vagina and placing it in a culture medium to enable growth of existing bacteria or fungi. The culture is later analysed to identify the organisms and determine their sensitivity to antibiotics or antifungal drugs. The test is done to confirm a diagnosis of vaginal infections and help in treating them.

Culture Ear Swab and Sensitivity
An ear swab culture consists of taking a sample of the organism from the ear canal and putting it into a culture medium that encourages the growth of bacteria or fungi. The culture is then examined to identify the organisms and to determine their sensitivity to antifungal and antibiotic drugs. This test is useful in determining the diagnosis of ear infections and helps to treat them.

ACTH (Adrenocorticotropic Hormone)
ACTH is a hormone produced by the pituitary gland which also stimulates the adrenal glands to secrete cortisol. An ACTH test determines the blood concentration of ACTH which may assist to diagnose some diseases of adrenal glands or pituitary gland.

Cortisol
The metabolic processes of the body, particularly the immune system and the stress response, are managed and monitored through the hormone cortisol, which is obtained from the adrenal gland. Through blood tests, the conditions associated with heightened secretion or insufficient production of adrenocorticotropic hormone, such as Cushing’s syndrome and adrenal insufficiency, respectively, can be determined through the measurement of cortisol levels.

Estradiol (E2)
Being one of the most important estrogens, estradiol is manufactured in the ovaries and is involved in the maintenance of the reproductive system and controls the menstrual cycle. It is also possible to examine the estradiol levels in the blood for receiving information concerning a patients fertility, stage of menopause, and even some malignancies.

Insulin, Fasting
The fasting insulin test is specifically tailored towards checking estrogen levels after an overnight fasting period. One of its primary uses is diagnosing insulin resistance. It is also useful in checking the amount of insulin in animals suffering from diabetes.

Insulin, Postprandial
The post-prandial insulin test is vital in measuring the amount of insulin in a patient after they consume a meal. Insulin response is crucial in confirming insulin resistance.

Lactic Dehydrogenase (LDH)
LDH is an enzyme within the heart, liver and muscle tissues. An LDH test determines the concentration of this enzyme in the blood which indicates possible tissue damage or other conditions.

Progesterone, Serum
Progesterone is produced by the ovaries in females and the testes in males. A serum progesterone test assesses progesterone concentration in blood to evaluate fertility, pregnancy, and other hormonal disorders.

Testosterone, Serum
Testosterone is made within the testes of males and also in the ovaries of females. A serum testosterone test assesses the testosterone concentration and aids in the diagnosis of lower than normal testosterone levels and other related disorders.

Parathyroid Hormone (PTH)
PTH is a hormone secreted by the parathyroid glands whose function is to control calcium and phosphorus levels in the blood. A blood test of PTH measures the amount of PTH in blood and along with other tests, can assess parathyroid hormone related disorders as well as calcium metabolic disorders.

T3, Total
Total T3 (triiodothyronine) refers to total T3 hormone in the blood, both bound and free. It aids in evaluating thyroid function and diagnosing its disorders.

TSH (Thyroid-Stimulating Hormone)
TSH is a product of the pituitary gland and it is responsible for stimulating the thyroid to produce its hormones. A TSH test checks whether TSH levels in the blood are normal. This is useful for diagnosing various thyroid disorders such as hypothyroidism and hyperthyroidism.

T3, Free (fT3)
Free T3 (triiodothyronine) is a form of T3 hormone that circulates unbound to proteins in the blood. It is useful in assessing thyroid function and diagnosing thyroid disorders.

T4, Free (fT4)
Free T4 (thyroxine) is the unbound fraction of T4 hormone in the blood. It helps assess thyroid function and diagnose thyroid disorders.

Fluid Examination Routine
It involves the examination of body fluids, blood, urine, or joint fluids under a microscope. It aids in the diagnosis of infections, inflammation, and other conditions involving the fluid.

Fine Needle Aspiration Cytology (FNAC)
FNAC is a procedure that requires only minimal invasion and uses a thin needle to remove cells from a lump or mass. FNAC is useful in diagnosing tumors, infections, and inflammatory conditions after the cells are microscopically examined.

Histopathology, Biopsy Soft Tissue
This procedure is concerned with the removal and microscopic examination of a small piece of soft tissue like skin and muscle. It contributes in the diagnosis of tumors, infections, and inflammatory conditions.

Histopathology, Biopsy Bone
This procedure deals with the removal of a sample of bone tissue for microscopic examination. It aids in the diagnosis of bone tumours, infections, and other conditions of the bone.

Vaginal Cytology
This procedure consists of taking cell samples from the vaginal wall of a female animal and looking at them through a microscope. It helps to evaluate the stage of the oestrous cycle, reproductive tract infections, and issues surrounding fertility.

Skin Scraping Test
It is a test in which he scrapes the surface of the skin to get samples of skin cells, hair, and washings. The sample is then microscopically checked for mites or lice, which are external parasites.

Blood Smear – Protozoa
The blood smear test begins with placing a drop of blood, spreading it uniformly across a slide, and staining it. After this, the blood cells are analysed with a microscope. This test helps in diagnosing the presence of parasitic protozoa like Babesia or Trypanosoma in the blood.

Stone Analysis
Stone analysis is the evaluation of a sample of a urinary stone (calculi) that has been surgically extracted from the urinary tract. The stone is examined to establish its constituents, which determines treatment measures as well as preventive actions to be taken to avoid reoccurrence.

Urine, R/E (Routine Examination)
Urinalysis specimens are examined for such things as color, cloudiness, specific gravity, ph, protein concentration, glucose, ketones, bilirubin, urobilinogen, nitrites, leukocytes and erythrocytes. A urine test is useful in proving a urinary tract infection and kidney infections among others.

Stool, R/E (Routine Examination)
The basic metabolic panel consists of sodium, potassium, chloride, bicarbonate, glucose, blood urea nitrogen (BUN), and creatinine. The results are useful in the evaluation of the patient’s fluid status, cardiac and kidney functions, as well as electrolytic balance.

C-Reactive Protein (CRP)
CRP is a protein produced by the liver in response to inflammation. A CRP test measures the level of CRP found in the blood, which can aid in the diagnosis and treatment of inflammatory diseases of pets.

Alpha-Fetoprotein (AFP)
An increase of AFP in blood could also point to some malignancies, such as liver carcinoma, in pets.

IgM Immunoglobulin, Serum
Serum IgM can be checked to evaluate the levels of IgM antibodies specific to the infected tissues, thus verifying the diagnosis of acute infections.

IgG Immunoglobulin, Serum
The most common type of antibody in the blood is IgG, and it is produced after an infection or vaccination. A serum IgG test determines the amount of IgG antibodies and is useful in evaluating total immunity and response to vaccines in animals.

IgA Immunoglobulin, Serum
IgA is an antibody that lines the respiratory and gastrointestinal tracts. The serum IgA test quantifies the IgA antibodies in the blood and can be used to evaluate some immune disorders in animals.

IgE Immunoglobulin, Serum
Triggering allergic reactions, IgE is the antibody responsible for such functions. A serum IgE test evaluates the concentration of IgE antibodies in the blood and so assists in the diagnosis of allergies and monitoring response to allergy treatment in animals.

Leishmania Antibody IgG
Sandflies transmit the parasitic disease leishmaniasis. The Leishmania antibody IgG test identifies antibodies against the parasite in the blood, which assists with the diagnosis of leishmaniasis in pets.

Troponin I
The protein Troponin I is present within the heart muscles. In animals, an elevated concentration of troponin I in the bloodstream indicates the destruction of heart muscle tissue, for instance, in a myocardial infarction.

Feline Leukemia Virus (FeLV)
FeLeuk is an immunosuppressive retrovirus that infects felines. For Felv, the viremia is detected by finding its antigens or antibodies in blood, saliva, and bone marrow. Tests for the presence of Felv are valid for all cats exposed to the virus, especially outdoor cats or those cohabiting with Felv-positive cats.

Rivalta Test
The Rivalta test is performed to detect the presence of excess protein or fibrinogen in body fluids like ascites or pleural effusion. The method entails the addition of a few drops of acetic acid into the fluid and observing for a gelatinous solid precipitate. This test is used to determine some conditions of feline infectious peritonitis (FIP).

Bilirubin, Direct
Bilirubin is produced as a waste product when red blood cells are metabolised. Direct bilirubin is one form of bilirubin that has been processed (conjugated) by the liver. A direct bilirubin test assesses the concentration of direct bilirubin in the blood. Raised values may suggest liver disorders or diseases of the bile duct.

Bilirubin, Total, Direct & Indirect
This test assesses the concentration of total bilirubin, direct, and indirect bilirubin separately in the blood. It gives a better understanding of the constituents, which aids in the diagnosis of some specific liver or bile duct ailments.

Blood Urea Nitrogen (BUN)
BUN is a form of waste, a product of liver metabolism, and is excreted from the kidneys. A blood BUN test tells us the quantity of urea nitrogen in blood and thus, can determine the enzymatic activity of the kidneys.

Cholesterol, HDL
HDL values are referred to as ‘good’ cholesterol since its primary function is to lessen the quantity of LDL cholesterol in the body. An HDL cholesterol test determines the amount of the so-called good cholesterol present in the blood.

Calcium, Serum
Calcium, along with other minerals that help with bone health, muscle functionality and bodily nerve actions. Furthermore, it requires a serum calcium test, which helps ascertain the quantitative value of calcium contained in blood to evaluate calcium levels for bones, kidneys, and even other parts of the body.

Chloride, Serum
Serum Chloride helps maintain blood volume while also being significant in monitoring the state of tissues and fluid on bursting and having sedated tissues at various points. Disorders such as dehydration can be measured by a serum chloride test.

Cholesterol, LDL
LDL cholesterol refers to the type of cholesterol that raises concern, due to its association with determining the likelihood of a person suffering a stroke or heart attack. Hence, An LDL cholesterol test is to identify or measure the extent of the risk of arteries being blocked by cholesterol.

Cholesterol, Total
Total Cholesterol measures the amount of lipid ratios together with the HDLS and LDLS. Heart diseases will without a doubt arise in individuals with increased accumulated plaque in their blood vessels, resulting from high rates of total cholesterol.
Our vet specialists
If you’re looking for a trusted veterinary clinic that prioritises your pet’s health and happiness, look no further than PetYaari Pet Clinic. Our team is ready to provide the highest standard of care for your furry family members.
Contact us
Petyaari Pet Clinic guarantees that every pet is well taken care of, providing the utmost care and service needed. These services include routine checkups. Complex surgeries and swift emergency response are tailored to meet the unique requirements of each pet.
Call Us: +91-9959337244
petyaari.com@gmail.com
Road No 6, Chaitanya Nagar, Phase 2, B N Reddy Nagar, Hyderabad, Telangana 500079



